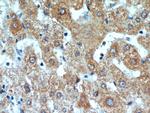
C16orf70 Antibody in Immunohistochemistry (Paraffin) (IHC (P))

Search
Proteintech
C16orf70 Polyclonal Antibody
{{$productOrderCtrl.translations['antibody.pdp.commerceCard.promotion.promotions']}}
{{$productOrderCtrl.translations['antibody.pdp.commerceCard.promotion.viewpromo']}}
{{$productOrderCtrl.translations['antibody.pdp.commerceCard.promotion.promocode']}}: {{promo.promoCode}} {{promo.promoTitle}} {{promo.promoDescription}}. {{$productOrderCtrl.translations['antibody.pdp.commerceCard.promotion.learnmore']}}
产品信息
20602-1-AP
种属反应
宿主/亚型
分类
类型
抗原
偶联物
形式
浓度
纯化类型
保存液
内含物
保存条件
运输条件
产品详细信息
The MW of this protein is 48 kDa, and our antibody specifically recognizes the 48 kDa protein.
Immunogen sequence: NQRLKVIEV CDLTKVKLKY CGVHFNSQAI APTIEQIDQS FGATHPGVYN SAEQLFHLNF RGLSFSFQLD SWTEAPKYEP NFAHGLASLQ IPHGATVKRM YIYSGNSLQD TKAPMMPLSC FLGNVYAESV DVLRDGTGPA GLRLRLLAAG CGPGLLADAK MRVFERSVYF GDSCQDVLSM LGSPHKVFYK SEDKMKIHSP SPHKQVPSKC NDYFFNYFTL GVDILFDANT HKVKKFVLHT NYPGHYNFNI YHRCEFKIPL AIKKENADGQ TETCTTYSKW DNIQELLGHP VEKPVVLHRS SSPNNTNPFG STFCFGLQRM IFEVMQNNHI ASVTLYGPPR PGSHLRTAEL P (73-422 aa encoded by BC004556)
靶标信息
C16orf70 (Chromosome 16 Open Reading Frame 70) is a Protein Coding gene. An important paralog of this gene is TBC1D32. [GeneCards]
仅用于科研。不用于诊断过程。未经明确授权不得转售。
篇参考文献 (0)
生物信息学
蛋白别名: lin-10 homolog; Phagosome assembly factor 1
基因别名: C16orf6; C16orf70; lin-10; LIN10; PHAF1
UniProt ID: (Human) Q9BSU1
Entrez Gene ID: (Human) 80262